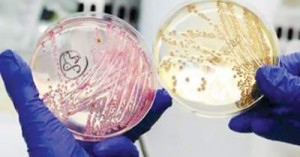

Hỗ trợ trực tuyến
Hotline: 0935.15.14.17 | |
Hotline: 0903.423.691 | |
Mr.Dung | |
Mr.Toanh |
Thông tin cần biết
Đối tác
Tin tức
TP.HCM: Sẽ kiểm tra chất DEHP trên phụ gia và thực phẩm
- Chi cục Vệ sinh An toàn Thực phẩm TP. HCM sẽ phối hợp với thanh tra Sở Y tế TP. HCM tiến hành kiểm tra chất DEHP trên phụ gia và thực phẩm. Ngày 5/6, ông Huỳnh Lê Thái Hòa - Chi cục Trưởng Chi cục Vệ sinh An toàn Thực phẩm TP. HCM cho biết, nhằm đảm bảo sức khỏe cho người tiêu dùng, Chi cục sẽ phối hợp với thanh tra Sở Y tế TP. HCM tiến hành thanh tra, lấy mẫu xét nghiệm kiểm tra chất DEHP trên các phụ gia thực phẩm và các loại thực ...
Xem chi tiết >>Rửa mặt khi đi nắng về có thể gây đau đầu
Thói quen rửa mặt ngay sau khi đi nắng về có thể là nguyên nhân khiến bạn đau đầu. Việc hoạt động, chơi thể thao ngoài nắng làm cơ thể thoát ra nhiều mồ hôi. Nhiều người về nhà, khi thấy đầu, mặt nóng bức khó chịu là muốn tắm, gội đầu, rửa mặt ngay cho mát mẻ. Thế nhưng, cảm giác dễ chịu chỉ là được một lúc và không lâu sau, đầu, mặt có thể sẽ nóng trở lại cùng chứng đau đầu. Vài viên thuốc giảm đau có thể giúp xoa dịu cơn đau. Tuy nhiên những ...
Xem chi tiết >>
E.Coli biến chủng gây dịch nguy hiểm thế nào?
LTS: Thông tin mới nhất (ngày 2/6/2011) từ Tổ chức Y tế thế giới (WHO) cho biết, vi khuẩn E.Coli bị coi là thủ phạm gây dịch nhiễm khuẩn đường ruột tại châu Âu hiện nay là một chủng vi khuẩn mới, chưa từng được phát hiện ở bệnh nhân trước đây. Kết quả sơ bộ việc phân tích chuỗi gen cho thấy, chủng vi khuẩn mới này là dạng đột biến của hai chủng vi khuẩn E.Coli khác nhau. Chúng có những đặc tính khiến trở nên nguy hiểm hơn nhiều so với hàng trăm loại chủng vi khuẩn ...
Xem chi tiết >>Truy tìm “bệnh lạ” ở Quảng Ngãi
Sự xuất hiện bệnh lạ ở xã Ba Điền, huyện Ba Tơ khiến người dân lo lắng. Lòng bàn tay của các bệnh nhân bị dày sừng Tin từ sở Y tế Quảng Ngãi ngày 4/6 cho biết, hơn 2 tuần qua, Trung tâm Chống độc Bạch Mai, Bệnh viện Tim mạch Trung ương, Trung tâm Huyết học truyền máu Quốc gia và Bệnh viện Da liễu Trung ương cùng hội chẩn để xác định căn bệnh lạ xảy ra đối với các bệnh nhân thuộc 3 gia đình ở xã Ba Điền, huyện miền núi Ba Tơ nhưng đến nay vẫn ...
Xem chi tiết >>Thêm nhiều thực phẩm được kiểm tra chất tạo đục độc hại
- Trước nguy cơ phụ gia chứa hóa chất độc có thể gặp ở nhiều sản phẩm khác, Cục ATVSTP đã mở rộng nhóm danh mục thực phẩm cần kiểm nghiệm. Theo đó, một loạt sữa chua, bánh kẹo, thạch hoa quả… đã được lấy mẫu để kiểm nghiệm. Hôm 29/5, Cục An toàn vệ sinh thực phẩm đã lấy mẫu ngẫu nhiên các loại nước rau câu Long Hải, Sữa chua Ba vì, Sữa tươi Ba vì, Thạch sữa chua 319, Thạch rau câu câu… để kiểm nghiệm tìm chất DEHP. Kết quả kiểm nghiệm được Viện Kiểm nghiệm An ...
Xem chi tiết >>Melatonin và sinh sản
MỘT SỐ THÔNG TIN CHUNG VỀ MELATONIN Melatonin là một thuốc được sử dụng rộng rãi (bán không cần đơn) ở nhiều nước trên thế giới, đặc biệt là ở Mỹ. Bản chất melatonin là một nội tiết tố tự nhiên do cơ thể tiết ra. Melatonin thường được tiết nhiều vào ban đêm. Các nghiên cứu cho thấy sự chế tiết melatonin trong cơ thể giảm dần theo tuổi. Melatonin được sử dụng phổ biến nhất trong việc điều hòa giấc ngủ và giúp chống tác hại của các gốc oxy hóa (anti-oxidant). Viện nghiên cứu Sinh học và Y học ...
Xem chi tiết >>